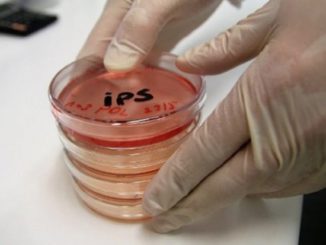

Política
Desde México, Patiño dice que «el fin del gobierno está cerca»
El excanciller Ricardo Patiño se ha pronunciado desde la clandestinidad, en un vídeo difundido en redes sociales, sobre la orden de detención dictada en su contra la tarde de este jueves, tras la audiencia de […]